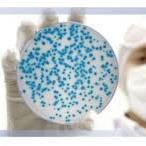

Subs10 @_kpeace
Just here for the lulz Toronto, Ontario Joined September 2009-
Tweets2K
-
Followers134
-
Following328
-
Likes51
How does mayonnaise promote browning on a grilled cheese? May-ard reaction #sadsubzijokes
If you're Level 40 in Season 1... RT this tweet
Reddit>Twitter. How else would I learn that 50 terrorists ended up killing themselves last week in 2 separate comical incidents?
After watching Mission impossible fallout and Alec Baldwin’s crazy head of hair at his age, he should change his name to Alec Not Bald- WIN!
Observation 3: What if this is just phase 1 of the zombie apocalypse?
Observation 2- This whole thing kinda makes terrorism obsolete. You can likely cause far more terror these days by coughing on a highly used publicly accessible surface instead of waving a gun around.
All this social distancing genuinely calls for more social media to air empty thoughts and #sadsubzijokes
Apparently Ole Gunnar Solskjaer has just been caught speeding heading back to Manchester on the A1. When the policeman asked why he was going so fast he said: "It's about the only way I can get 3 points at the moment"
It’s pretty ironic that one of the most real shows I’ve watched lately is an animated series starring an anthropomorphic horse. #netflixbacklog #BoJackHorseman
Yeesh, 8 seasons and all that convoluted shit just to show everyone that if you’re a nice guy, you might be miserable, but your kids will turn out great. #GameOfThronesFinale
Jesus Christ game of thrones. That’s the greatest tv moment of all time.
So true. Also moving abroad with pets vs children. 🙄
All you have to do for #PAXGPsweepstakes: retweet this and follow us. what you could win: one of these custom consoles one year of Xbox Game Pass one year of Xbox Live Gold a special place in our hearts details: xbx.lv/2WnGzmr

Goutham Sunny @gsrocks007
11 Followers 177 Following 🇮🇳, Medical Oncologist, Leia’s dada, MV33, Fountain pen enthusiast, AI and Big Data, Coffee addict, Foodie. Official account @medoncodoc
princess tailoring st... @ptsraikot
396 Followers 1K Following
MAA VAISHNO BALLOON D... @AnkitPa82362837
10 Followers 52 Following EVENTS PLANNER Balloon decoration flower decorations dj and music stysm boncey jhula jumping jhula gun shooting game magic show Birthday party theme decor
Chosen @Iam_Olushina
468 Followers 4K Following I be Electrician, We are experts in conduit & Surface wiring and we also maintain properties. @Elite247eletric
kumar Varun @Globaleventguy
136 Followers 1K Following मस्तमौला I Mast-maula EVENT CURATOR BY PROFESSION, PATRIOT BY PASSION
umesh kumar @umiiumesh
3 Followers 102 Following
Aniruth @AniruthRealMe
21 Followers 87 Following
Cricket Critic @cricritiq
14 Followers 40 Following Critical views on cricket. Team before self, always. 4th innings century fanatic
yuloshop @yuloshop_21
8 Followers 67 Following
Arun Babu TB @arun1989_
1 Followers 51 Following
Sunil S. Patwardhan @SunilSPatwardh1
12 Followers 87 Following
Uma Shankar @UmaShan04746518
26 Followers 77 Following
Shruti Patki @patkishruti
9 Followers 46 Following
Savish @savishsatz17
7 Followers 108 Following
C.S.ABHILASH @Constantine839
169 Followers 156 Following Commodity Leader- Hydraulics and Powertrain- Doosan Bobcat MBA-ESB Business school Reutlingen
K @kelzkhaleesi
19 Followers 56 Following
Tshering Wangdi @tsheing
62 Followers 114 Following
Mitansh Agrawal @MitanshAgrawal
28 Followers 70 Following Brands Business & CEOs Leagues and Teams Sports Business and Financial News
amit purohit @amitlonesoldier
298 Followers 1K Following Digital Transformation | Product | Dreamer | Believer | StoryTeller Book a 1:1 mentorship call with me today @ https://t.co/jdbWet7xCc
SHASHI KANT SHUKLA @SHASHIK13626362
27 Followers 425 Following
Caleb @calebtoyese
148 Followers 755 Following
Rajesh Patel @rajpatelts
5 Followers 224 Following Life is beauty. Don't waste it, enjoy each movement without comparing with others.
shawn james @nwahsnelvin
15 Followers 51 Following
karthik @karthikchilukur
1 Followers 23 Following
शराबी~ @dheet_punjabi
332 Followers 529 Following शराबी को कहा होश कुछ बताने की। वो तो पीये जा रहा है ज़िन्दगी जिए जा रहा है।
venkat @merivenkat15
5 Followers 212 Following
Pradeep Mohan Rao @pradeepcat1989
6 Followers 75 Following
pramod khadse @pramodkhadse20
17 Followers 611 Following
Ayyanar P @ayyanarmari101
41 Followers 915 Following
naveen raj @b6f86bf3b2b2428
53 Followers 593 Following
balaji bala @balajigomu9455
8 Followers 329 Following
biplab boro @borobiplab
75 Followers 592 Following
narayan@prettykrafts @prettykrats
17 Followers 339 Following
Jeevan Kumar @jeevan_ku_m_ar
17 Followers 117 Following
Mayor Olivia Chow �... @MayorOliviaChow
22K Followers 201 Following Mayor of Toronto. Former City Councillor, Member of Parliament, and school trustee. For assistance, email [email protected].
Olivia Chow @oliviachow
141K Followers 2K Following Former City Councillor, Member of Parliament, and school trustee. Personal account.
SHAQ @SHAQ
15.4M Followers 858 Following VERY QUOTATIOUS, I PERFORM RANDOM ACTS OF SHAQNESS @djdiesel
Toronto Police Operat... @TPSOperations
321K Followers 3 Following Official @TorontoPolice Operations Centre ***NOT MONITORED 24/7***. Non Emergency number is 416-808-2222, Emergency 911, TDD 4164670943
Toronto Vaccination U... @VaxToronto
6K Followers 18 Following Community-run vaccination clinic updates for Toronto. Media inquiries: [email protected] Other affiliated accounts: @VaxYork @VaxDurham @VaxPeel
Vaccine Hunters Ontar... @VaxHuntersON
42K Followers 40 Following Ontario COVID-19 vaccination information Follow the primary #COVID19Vaccine resource @VaxHuntersCan for Canada wide updates Not affiliated with @vaxhunterscan
NintendoSoup @ninsoup
37K Followers 106 Following For the latest Switch, 3DS, Pokemon and Nintendo news, visit our home on the web at https://t.co/bmTUZhvk9Y
Virtual Pro Gaming @OfficialVPG
39K Followers 2K Following 🏠 The Home of Competitive 11v11 Clubs since 2016. 💰$350k+ on cash prizes. 📱 Download our mobile app! - 🏆 @VPGPremier @VPGEurope #WhereTheChampionsPlay
Vaccine Hunters Canad... @VaxHuntersCan
215K Followers 19 Following Helping eligible Canadians find vaccines. See who's on our team here: https://t.co/AYbOrfHQqU. Media Inquiries: media AT vaccinehunters DOT ca
Tommy Wiseau @TommyWiseau
234K Followers 4 Following Screenings-The Room - Big Shark - https://t.co/JK15lOokSr American Actor / Fashion Designer / Director / Creator of THE ROOM & BIG SHARK theroom@theroommovie.
Xbox Canada @XboxCanada
196K Followers 229 Following The official Twitter profile of Xbox Canada. For all Technical Support issues, please reach out to @XboxSupport
Andrew Phung @andrewphung
49K Followers 1K Following @RunTheBurbs on @CBCgem and @hulu | Kimchee on @KimsConvenience | LOL: 🇨🇦 on Prime Video | Comedian/Improviser | Dad | Sneakers❤️ | IG: @andrewphung | 🦃🦃🌮
RAHUL SAWANT @RahulVSawant
47 Followers 185 Following PhD Physics. Quantum Technology and Science research. 🇮🇳
PlayStation Canada @PlayStationCA
143K Followers 417 Following Official Canadian Twitter updates on PlayStation, PS4, PS5, PS VR, PlayStation Store and more. Support: @AskPlayStation
BBY Canada Gamers @BBYC_Gamers
189K Followers 1K Following The official Twitter handle for Best Buy Canada Gaming deals. Follow for hot gaming offers, latest news, giveaways & more!
EB Games Canada @ebgamescan
164K Followers 712 Following Live support Mon-Fri 9am-5pm ET | Assistance en direct lun-ven, 9am-5pm. HE ! Reach us//contactez nous: [email protected]
Walmart Canada Gaming @WalmartCAGaming
169K Followers 326 Following The official X page of Walmart Canada Gaming. Follow us for gaming news, product information and more! | Customer service needs should message @WalmartCanada.
Shoppers Drug Mart @ShopprsDrugMart
82K Followers 3K Following Shoppers Drug Mart has over 1,300 stores across Canada, making life easier for Canadians. Customer Care/assistance available M-F 8-7 EST and S-S 10-6 EST
Mike Wang @Beluba
567K Followers 31 Following 2K Sports - Gameplay Director for NBA 2K (the views I express are mine alone and they do not reflect the views of 2K)
Whole Karen Disposal ... @thewholekaren
6K Followers 21 Following Need to dispose of a Karen? we have a van for that! You tweet em we yeet em! Also the HQ of the Good Karens & the Convent of the Little Sisters of St. Yeetus
Whole Man Disposal Se... @WholeManDispose
23K Followers 11 Following Need to throw away the whole man? We are Whole Man Disposal - the fourth emergency service. Vans dispatched regularly.
GO Transit Bus @GOtransitBus
7K Followers 9 Following @GOtransitBus: Updates on planned service changes, construction and more. For real-time service updates, sign up for On the GO alerts https://t.co/Bec3rFbLFz
Ball is Bae NBA Podca... @BallisBaePod
145 Followers 121 Following Covering the NBA 🏀 in an Indian accent since 2017. Run by madmen @njan_Ashwin and @VineetDevaiah
Harish Iyengaar @scaryhairyman
9K Followers 1K Following Corporate Communications Manager at @UbisoftIn 👨💻 Video Games 🎮 Guitar 🎸 Dogs 🐕 Opinions are my own.
President-Elect Super... @PresVillain
58K Followers 3 Following I take real Trump quotes and photoshop them into comics. Consider some QUID PRO QUO: https://t.co/kay6h7IQ7D. Created by D.M. Higgins.
Bindi Irwin @BindiIrwin
719K Followers 6 Following Her heart bloomed sunflowers so she would always face the light. ☀️️🌻🐨 For all business enquiries contact - [email protected]
Terri Irwin @TerriIrwin
368K Followers 188 Following Mother, conservationist, owner of @AustraliaZoo For business/filming/media enquiries please contact [email protected] I don’t have Facebook.
Robert Irwin @RobertIrwin
704K Followers 149 Following Official Twitter - ☀️🐊 Keep up with my latest adventures [email protected]
TTC Customer Service @TTChelps
77K Followers 22 Following @TTChelps 7 days-a-week or call 416-393-3030 from 7am-10pm. @TTCnotices for service alerts https://t.co/x7I4A3J1gE. Use SafeTTC App for safety concerns
TTC Service Alerts @TTCnotices
480K Followers 41 Following Service alerts from TTC Transit Control. Follow @TTChelps for customer service.
Xbox Game Pass @XboxGamePass
1.9M Followers 35 Following come for the games, stay for even more games
Vir Das @thevirdas
7.5M Followers 161 Following Comedian/Actor/Weirdass Comedy/ Biscuit Lover. My new NETFLIX SPECIAL, FOOL VOLUME! 👇 https://t.co/qIttfHaG89 WEBSITE: https://t.co/TtAHmwmbUq
The Witcher @thewitcher
1.6M Followers 102 Following Welcome to the official X account for The Witcher franchise and The Witcher 4, the upcoming open-world RPG developed by CD PROJEKT RED.
Strategy& @strategyand
112K Followers 379 Following Strategy& is a global team of practical strategists committed to helping you seize essential advantage. We are part of the @PwC network.
Jez @JezCorden
157K Followers 935 Following exec editor @WindowsCentral, @WinC_Gaming | podcaster @XB2podcast, @Unshackled_Fury | beat: Xbox, Windows, Microsoft. | links: https://t.co/qhP4PzPx7h
Rand al Thor 19 @Rand_al_Thor_19
42K Followers 619 Following Xbox YouTube Content Creator with 100K+ subscribers | Host of The Xbox Two Podcast | Contact: [email protected]
CD PROJEKT RED @CDPROJEKTRED
1.3M Followers 56 Following The official Twitter account for CD PROJEKT RED - the developer of critically acclaimed RPGs, The Witcher franchise and Cyberpunk 2077.
Cyberpunk 2077 @CyberpunkGame
1.9M Followers 114 Following Welcome to the official X account of #Cyberpunk2077 and its spy-thriller expansion #PhantomLiberty developed by @CDPROJEKTRED
r/AssassinsCreed @rAssassinsCreed
10K Followers 13 Following The official Twitter account of the Assassin's Creed Reddit Community. Auto-tweeting new posts daily, and managed by the Moderators
Assassin's Creed @assassinscreed
4.7M Followers 264 Following Assassin's Creed Shadows. Available Now: https://t.co/mTO1en6D1g
Tencent 腾讯 @TencentGlobal
52K Followers 23 Following Tencent uses technology to enrich the lives of Internet users.
PUBG: BATTLEGROUNDS @PUBG
1.8M Followers 36 Following Official Twitter for PUBG: BATTLEGROUNDS || Player Support: https://t.co/PCTNwl96lH || #ThisIsBattleRoyale #PUBG